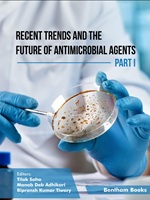

Patents

6. Drug composition/combination for the treatment of Huntington’s disease (HD) and spinocerebellar ataxias(SCA) (IN590970)
5. A DRUG COMBINATION FOR THE TREATMENT OF SEVERE NEURODEGENERATIVE DISEASES (APPLICATION NO: 202421100305)
4. DRUG COMPOSITION/COMBINATION FOR EFFECTIVE THERAPEUTIC TREATMENT AND METHOD THEREOF. (APPLICATION NO: 202421100304)

3. A DRUG COMBINATION FOR EFFECTIVE THERAPEUTIC TREATMENT AND METHOD THEREOF. (IN572468)

2. A DRUG COMBINATION FOR EFFECTIVE THERAPEUTIC TREATMENT AND METHOD THEREOF. (IN573597)

1. PEPTIDES-BASED DRUG AND METHOD THEREOF. (IN564994)
Publication List

117. Chakraborty, A., & Kumar, A*. (2026). Structure-based identification of natural small molecules as potential CTLA4 inhibitors: A computational approach. In Silico Research in Biomedicine, 2, 100432. https://doi.org/10.1016/j.insi.2026.100432

116. Chetia, P., & Kumar, A*. (2026). Targeting promoter G-quadruplex of SIRT3 with valsartan and candesartan as a therapeutic strategy to downregulate its expression in lung cancer. International Journal of Biological Macromolecules, 152766. https://doi.org/10.1016/j.ijbiomac.2026.152766

115. Karati, S., Rawat, S., Kumari, A. P., Das, S., Shukla, S., & Kumar, A*. (2026). The Tale of the Guanosine Tract in Repeat Expansion Disorders. Molecular Neurobiology, 63(1), 480. https://doi.org/10.1007/s12035-026-05735-w

114. Chakraborty, A., Dasgupta, M., Joshi, A., Sharma, T. K., & Kumar, A*. (2025). Peptide Aptamers: A Novel Potential Tool Against Viruses. International Journal of Peptide Research and Therapeutics, 32(1), 13. https://doi.org/10.1007/s10989-025-10795-y

113. Singh, A., Patel, M., Sharma, T. K., & Kumar, A*. (2025). G-Quadruplex structures within the hfq gene regulate RNA–protein interactions in Acinetobacter baumannii. Journal of Structural Biology, 108265. https://doi.org/10.1016/j.jsb.2025.108265

112. Das, S., Kumari, A. P., Singh, K., Shukla, S., Khandelwal, S., & Kumar, A*. (2025). Molecular Repositioning of Celecoxib as a Neurotherapeutic Agent in Fragile X-Associated Tremor/Ataxia Syndrome (FXTAS). ACS Pharmacology & Translational Science, acsptsci.5c00326. https://doi.org/10.1021/

111. Das, S., Patel, M., Khandelwal, S., Rawat, R., Shukla, S., Kumari, A. P., Singh, K., & Kumar, A*. (2025). From Mutations to Microbes: Investigating the Impact of the Gut Microbiome on Repeat Expansion Disorders. Journal of neurochemistry, 169(11), e70278. https://doi.org/10.1111/jnc.70278

110. Das, S.; Khandelwal, S.; Shukla, S.; Kumar, A*. Exploring the Pleiotropic Effects of lncRNA in Different Repeat Expansion Disorders. Biochimica et Biophysica Acta (BBA) – Molecular Basis of Disease 2025, 168089. https://doi.org/10.1016/j.bbadis.2025.168089.

109. Singh, K.; Shukla, S.; Kumari, A. P.; Qurashi, A.; Verma, A. K.; Kumar, A*. Repurposing Nitazoxanide to Target the Expanded r(CG)n Repeat RNA for Therapeutic Intervention in Fragile-X Tremor/Ataxia Syndrome. International Journal of Biological Macromolecules 2025, 329, 147864. https://doi.org/10.1016/j.ijbiomac.2025.147864.

108. Yadav, B.; Gaikwad, S. S.; Kumar, A.; Gupta, G. D.; Kumar, A.; Makde, R. D. Crystal Structure and Nucleic Acid Binding Activity of the Conserved UPF0235 Family Protein PF1765 from Pyrococcus Furiosus. Biochemical and Biophysical Research Communications 2025, 782, 152568. https://doi.org/10.1016/j.bbrc.2025.152568.

107. Singh, K.; Shukla, S.; Kumari, A. P.; Kumar, A*. Lacosamide Interaction with Expanded CGG Repeats RNA and Its Role in Modulating Poly-Glycine Protein-Mediated Toxicity in Fragile-X Tremor/Ataxia Syndrome. ACS Pharmacol. Transl. Sci. 2025, acsptsci.5c00198. https://doi.org/10.1021/acsptsci.5c00198.

106. Chetia, P.; Kumar, A*. From Unearthing to an Intriguing Cancer-Fighting Target: The Human BCL-2 Promoter G-Quadruplex and i-Motif. Biochimica et Biophysica Acta (BBA) – Reviews on Cancer 2025, 1880 (5), 189391. https://doi.org/10.1016/j.bbcan.2025.189391.

105. Chandravanshi, K.; Jamdar, S. N.; Singh, R.; Kumar, A.; Mahato, A.; Agrawal, R.; Kumar, S. A.; Kumar, A.; Makde, R. D. Structural and Functional Investigation of Putative Peptidase from Mycolicibacterium Phlei : An Exclusive Endopeptidase among S9C Subfamily. Biochemistry 2025, 64 (12), 2596–2610. https://doi.org/10.1021/acs.biochem.5c00047.

104. Choudhury, S. D.; Ghosh, S.; Kumar, P.; Bhardwaj, A.; Singh, K.; Singh, A.; Kumar, A.; Basu, B.; Giri, R.; Choudhury, D. Attenuation of C-Myc Expression in Breast Cancer by Hesperidin-Mediated Stabilization of Its Promoter Proximal G Quadruplex Region. International Journal of Biological Macromolecules 2025, 309, 143000. https://doi.org/10.1016/j.ijbiomac.2025.143000.

103. Chakraborty, A.; Kumar, A.* Computational Screening for Natural Compounds as Potential Immune Checkpoint Inhibitors against TIGIT, a New Avenue in Cancer Immunotherapy. Mol Divers 2025. https://doi.org/10.1007/s11030-025-11172-z.

102. Singh, K.; Shukla, S.; Ghosh, T.; Das, A. K.; Kumar, A.* Tyrosine Peptides Alleviates Multifaceted Toxicity Linked to Expanded CGG Repeats in Fragile X-Associated Tremor/Ataxia Syndrome. ACS Pharmacol. Transl. Sci. 2025. https://doi.org/10.1021/acsptsci.4c00647.

101. Singh, K.; Gupta, K.; Shukla, S.; Kumari, A. P.; Kumar, A.* Repurposing Oseltamivir Against CAG Repeat Mediated Toxicity in Huntington’s Disease and Spinocerebellar Ataxia Using Cellular and Drosophila Model. ACS Omega 2025, 10 (15), 14980–14993. https://doi.org/10.1021/acsomega.4c10338

100. Alam, M. S., Dhiman, A., Bhardwaj, T., Chatterjee, S., Lakra, V., Tripathi, M., Lohani, K., Sharma, Y. D., Mirdha, B. R., Kumar, A., Sharma, T. K., & Rathore, S. (2025). Aptamer-Based Diagnosis for Plasmodium vivax Specific Malaria. ACS Infectious Diseases, 11(3), 762–772. https://doi.org/10.1021/acsinfecdis.4c01047

99. Kumari, M., Jaiswal, S., Shankar, U., Gupta, S., Pradeepkumar, P. I., Kumar, A., Nayak, D., Yadav, V., & Yadav, P. (2025). Characterization of G‐quadruplexes in the Helicobacter pylori genome and assessment of therapeutic potential of G4 ligands. Biotechnology and Applied Biochemistry, 72(1), 29–42. https://doi.org/10.1002/bab.2644

98. Kumar, P., Kinger, S., Dubey, A. R., Jagtap, Y. A., Choudhary, A., Karmakar, S., Lal, G., Kumar, A., Bhattacharyya, S., Poluri, K. M., & Mishra, A. (2025). Ketorolac disturbs proteasome functions and induces mitochondrial abnormality‐associated apoptosis. IUBMB Life, 77(1), e2937. https://doi.org/10.1002/iub.2937

97. Shukla, S., Gupta, K., Singh, K., Mishra, A., & Kumar, A.* (2025). An Updated Canvas of the RFC1-mediated CANVAS (Cerebellar Ataxia, Neuropathy and Vestibular Areflexia Syndrome). Molecular Neurobiology, 62(1), 693–707. https://doi.org/10.1007/s12035-024-04307-0

96. Joshi, A., Kaushik, A., Taneja, N. K., Chauhan, K., Kumar, A., & Sharma, T. K. (2024). Development of novel DNA aptamers and colorimetric nanozyme aptasensor for targeting multi-drug-resistant, invasive Salmonella typhimurium strain SMC25. Biosensors and Bioelectronics: X, 21, 100555. https://doi.org/10.1016/j.biosx.2024.100555

95. Chandravanshi, K., Singh, R., Kumar, A., Bhange, G. N., Kumar, A., & Makde, R. D. (2024). Structural adaptations for carboxypeptidase activity in putative S9 acylaminoacyl peptidase from Bacillus subtilis. International Journal of Biological Macromolecules, 282, 136734. https://doi.org/10.1016/j.ijbiomac.2024.136734

94. Singh, K., Shukla, S., Shankar, U., Jain, N., Nag, R., Pramod, K. A., & Kumar, A.* (2024). Elucidating the pathobiology of Cerebellar Ataxia with Neuropathy and Vestibular Areflexia Syndrome (CANVAS) with its expanded RNA structure formation and proteinopathy. Scientific Reports, 14(1), 28054. https://doi.org/10.1038/s41598-024-78947-6

93. Singh, A., Majee, P., Mishra, L., Prajapat, S. K., Sharma, T. K., Kalia, M., & Kumar, A.* (2024). Role of RNA G-Quadruplexes in the Japanese Encephalitis Virus Genome and Their Recognition as Prospective Antiviral Targets. ACS Infectious Diseases, acsinfecdis.4c00507. https://doi.org/10.1021/acsinfecdis.4c00507

92. Jagtap, Y. A., Kumar, P., Dubey, A. R., Kinger, S., Choudhary, A., Karmakar, S., Lal, G., Kumar, A., Kumar, A., Prasad, A., & Mishra, A. (2024). Acetaminophen induces mitochondrial apoptosis through proteasome dysfunctions. Life Sciences, 349, 122732. https://doi.org/10.1016/j.lfs.2024.122732

91. Singh, A., Jain, N., Shankar, U., Sharma, T. K., & Kumar, A.* (2024). Characterization of G-quadruplex structures in genes involved in survival and pathogenesis of Acinetobacter baumannii as a potential drug target. International Journal of Biological Macromolecules, 269, 131806. https://doi.org/10.1016/j.ijbiomac.2024.131806

90. Chandravanshi, K., Singh, R., Bhange, G. N., Kumar, A., Yadav, P., Kumar, A., & Makde, R. D. (2024). Crystal structure and solution scattering of Geobacillus stearothermophilus S9 peptidase reveal structural adaptations for carboxypeptidase activity. FEBS Letters, 598(6), 684–701. https://doi.org/10.1002/1873-3468.14834

89. Kinger, S.; Jagtap, Y. A.; Kumar, P.; Choudhary, A.; Prasad, A.; Prajapati, V. K.; Kumar, A.; Mehta, G.; Mishra, A. Chapter Five – Proteostasis in Neurodegenerative Diseases. In Advances in Clinical Chemistry; Makowski, G. S., Ed.; Advances in Clinical Chemistry; Elsevier, 2024; Vol. 121, pp 270–333. https://doi.org/10.1016/bs.acc.2024.04.002.

88. Gupta, A., Mathew, R., Anand, A., Bhardwaj, T., Singh, A., Singh, K., Kumar, A., Mishra, P. R., & Sharma, T. K. (2024). A DNA aptamer-based assay for the detection of soluble ST2, a prognostic biomarker for monitoring heart failure. International Journal of Biological Macromolecules, 256, 128295. https://doi.org/10.1016/j.ijbiomac.2023.128295

87. Pandya, N., & Kumar, A.* (2023). An immunoinformatics analysis: Design of a multi-epitope vaccine against Cryptosporidium hominis by employing heat shock protein triggers the innate and adaptive immune responses. Journal of Biomolecular Structure and Dynamics, 41(23), 13563–13579. https://doi.org/10.1080/07391102.2023.2175373

86. Jain, N., Shankar, U., Singh, A., Sharma, T. K., & Kumar, A.* (2023). G-quadruplex motifs in Neisseria gonorrhoeae as anti-gonococcal targets. Applied Microbiology and Biotechnology, 107(16), 5145–5159. https://doi.org/10.1007/s00253-023-12646-6

85. Joshi, B., Kaur, J., Khan, E., Vishwakarma, S., Kumar, A., Joshi, D., Kumar, A., & Joshi, A. (2023). Alginate-based ‘nano-micro’ hybrid matrices developed using ultrasonic atomization for Co-delivery of chemotherapeutic drugs against superficial tumors. Journal of Drug Delivery Science and Technology, 84, 104532. https://doi.org/10.1016/j.jddst.2023.104532

84. Pandya, N., & Kumar, A.* (2023). A multi-epitope vaccine candidate developed from unique immunogenic epitopes against Cryptosporidium hominis by utilizing an immunoinformatics-driven approach. Journal of Biomolecular Structure and Dynamics, 41(10), 4614–4631. https://doi.org/10.1080/07391102.2022.2070284

83. Kinger, S., Dubey, A. R., Kumar, P., Jagtap, Y. A., Choudhary, A., Kumar, A., Prajapati, V. K., Dhiman, R., & Mishra, A. (2023). Molecular Chaperones’ Potential against Defective Proteostasis of Amyotrophic Lateral Sclerosis. Cells, 12(9), 1302. https://doi.org/10.3390/cells12091302

82. Joshi, B., Shankar, U., Vishwakarma, S., Kumar, A., Kumar, A., Joshi, D., & Joshi, A. (2023). Multifunctional Ultrasmall Theranostic Nanohybrids Developed by Ultrasonic Atomizer for Drug Delivery and Magnetic Resonance Imaging. ACS Applied Bio Materials, 6(5), 1943–1952. https://doi.org/10.1021/acsabm.3c00151

81. Pandya, N., & Kumar, A. (2023). Immunoinformatics analysis for design of multi-epitope subunit vaccine by using heat shock proteins against Schistosoma mansoni. Journal of Biomolecular Structure and Dynamics, 41(5), 1859–1878. https://doi.org/10.1080/07391102.2021.2025430
80. Majee, P., Kumar, A., & Nayak, D. (2023). Host Factors: New Dimension in Antiviral Drug Targeting. In Recent Trends and The Future of Antimicrobial Agents – Part I (pp. 263–282). Bentham Science Publishers. https://www.benthamdirect.com/content/books/9789815079609.chap10

79. Chauhan, N. K., Anand, A., Sharma, A., Dhiman, K., Gosain, T. P., Singh, P., Singh, P., Khan, E., Chattopadhyay, G., Kumar, A., Sharma, D., Ashish, Sharma, T. K., & Singh, R. (2023). Structural and Functional Characterization of Rv0792c from Mycobacterium tuberculosis: Identifying Small Molecule Inhibitor against HutC Protein. Microbiology Spectrum, 11(1), e01973-22. https://doi.org/10.1128/spectrum.01973-22

78. Pandya, N., Rani, R., Kumar, V., & Kumar, A.* (2023). Discovery of a potent Guanidine derivative that selectively binds and stabilizes the human BCL-2 G-quadruplex DNA and downregulates the transcription. Gene, 851, 146975. https://doi.org/10.1016/j.gene.2022.146975

77. Pandya, N., Singh, M., Rani, R., Kumar, V., & Kumar, A.* (2023). G-quadruplex-mediated specific recognition, stabilization and transcriptional repression of bcl-2 by small molecule. Archives of Biochemistry and Biophysics, 734, 109483. https://doi.org/10.1016/j.abb.2022.109483

76. Chauhan, P., Datta, I., Dhiman, A., Shankar, U., Kumar, A., Vashist, A., Sharma, T. K., & Tyagi, J. S. (2022). DNA Aptamer Targets Mycobacterium tuberculosis DevR/DosR Response Regulator Function by Inhibiting Its Dimerization and DNA Binding Activity. ACS Infectious Diseases, 8(12), 2540–2551. https://doi.org/10.1021/acsinfecdis.2c00414

75. Bhagwat, S. R., Choudhary, K., Pandya, N., Sharma, S., Srivastava, S., Kumar, A., & Hajela, K. (2022). Identification of substrates of MBL Associated Serine Protease-1 (MASP-1) from human plasma using N-terminomics strategy. Molecular Immunology, 151, 114–125. https://doi.org/10.1016/j.molimm.2022.09.001

74. Amanullah, A., Upadhyay, A., Dhiman, R., Singh, S., Kumar, A., Ahirwar, D. K., Gutti, R. K., & Mishra, A. (2022). Development and Challenges of Diclofenac-Based Novel Therapeutics: Targeting Cancer and Complex Diseases. Cancers, 14(18), 4385. https://doi.org/10.3390/cancers14184385

73. Shankar, U., Mishra, S. K., Jain, N., Tawani, A., Yadav, P., & Kumar, A.* (2022). Ni+2 permease system of Helicobacter pylori contains highly conserved G-quadruplex motifs. Infection, Genetics and Evolution, 101, 105298. https://doi.org/10.1016/j.meegid.2022.105298

72. Shankar, U., Jain, N., Mishra, S. K., Sk, M. F., Kar, P., & Kumar, A.* (2022). Mining of Ebola virus genome for the construction of multi-epitope vaccine to combat its infection. Journal of Biomolecular Structure and Dynamics, 40(11), 4815–4831. https://doi.org/10.1080/07391102.2021.1874529

71. Jain, N., Sk, M. F., Mishra, A., Kar, P., & Kumar, A.* (2022). Identification of novel efflux pump inhibitors for Neisseria gonorrhoeae via multiple ligand-based pharmacophores, e-pharmacophore, molecular docking, density functional theory, and molecular dynamics approaches. Computational Biology and Chemistry, 98, 107682. https://doi.org/10.1016/j.compbiolchem.2022.107682

70. Sharma, D., Sharma, S., Sinha, N., Jain, N., Kumar, A., Sarkar, A., Tyagi, J. S., & Gupta, R. K. (2022). Novel benzoic thiazolidin-4-one derivatives targeting DevR/DosR dormancy regulator of Mycobacterium tuberculosis. Journal of Molecular Structure, 1254, 132278. https://doi.org/10.1016/j.molstruc.2021.132278

69. Jain, N., Shankar, U., & Kumar, A.* (2022). Conserved G-Quadruplex Motifs Regulate Gene Expression in Neisseria meningitidis. ACS Infectious Diseases, 8(4), 728–743. https://doi.org/10.1021/acsinfecdis.1c00383

68. Verma, A. K., Khan, E., Mishra, S. K., & Kumar, A.* (2022). Small Molecule Screening Discovers Compounds that Reduce FMRpolyG Protein Aggregates and Splicing Defect Toxicity in Fragile X-Associated Tremor/Ataxia Syndrome. Molecular Neurobiology, 59(3), 1992–2007. https://doi.org/10.1007/s12035-021-02697-z

67. Dubey, A. R., Jagtap, Y. A., Kumar, P., Patwa, S. M., Kinger, S., Kumar, A., Singh, S., Prasad, A., Jana, N. R., & Mishra, A. (2022). Biochemical strategies of E3 ubiquitin ligases target viruses in critical diseases. Journal of Cellular Biochemistry, 123(2), 161–182. https://doi.org/10.1002/jcb.30143

66. Tamrakar, A., Singh, R., Kumar, A., Makde, R. D., Ashish, & Kodgire, P. (2021). Biophysical characterization of the homodimers of HomA and HomB, outer membrane proteins of Helicobacter pylori. Scientific Reports, 11(1), 24471. https://doi.org/10.1038/s41598-021-04039-4

65. Gupta, A., Anand, A., Jain, N., Goswami, S., Anantharaj, A., Patil, S., Singh, R., Kumar, A., Shrivastava, T., Bhatnagar, S., Medigeshi, G. R., & Sharma, T. K. (2021). A novel G-quadruplex aptamer-based spike trimeric antigen test for the detection of SARS-CoV-2. Molecular Therapy – Nucleic Acids, 26, 321–332. https://doi.org/10.1016/j.omtn.2021.06.014

64. Anand, A., Chatterjee, B., Dhiman, A., Goel, R., Khan, E., Malhotra, A., Santra, V., Salvi, N., Khadilkar, M. V., Bhatnagar, I., Kumar, A., Asthana, A., & Sharma, T. K. (2021). Complex target SELEX-based identification of DNA aptamers against Bungarus caeruleus venom for the detection of envenomation using a paper-based device. Biosensors and Bioelectronics, 193, 113523. https://doi.org/10.1016/j.bios.2021.113523

63. Pandya, N., Bhagwat, S. R., & Kumar, A.* (2021). Regulatory role of Non-canonical DNA Polymorphisms in human genome and their relevance in Cancer. Biochimica et Biophysica Acta (BBA) – Reviews on Cancer, 1876(2), 188594. https://doi.org/10.1016/j.bbcan.2021.188594

62. Kaur, J., Singh, R. R., Khan, E., Kumar, A., & Joshi, A. (2021). Piperine-Loaded PLGA Nanoparticles as Cancer Drug Carriers. ACS Applied Nano Materials, 4(12), 14197–14207. https://doi.org/10.1021/acsanm.1c03664

61. Pandya, N., & Kumar, A.* (2021). Piperine analogs arrest c-myc gene leading to downregulation of transcription for targeting cancer. Scientific Reports, 11(1), 22909. https://doi.org/10.1038/s41598-021-01529-3

60. Yadav, P., Kim, N., Kumari, M., Verma, S., Sharma, T. K., Yadav, V., & Kumar, A.* (2021). G-Quadruplex Structures in Bacteria: Biological Relevance and Potential as an Antimicrobial Target. Journal of Bacteriology, 203(13). https://doi.org/10.1128/JB.00577-20

59. Pandya, N., Jain, N., & Kumar, A.* (2021). Interaction analysis of anti-cancer drug Methotrexate with bcl-2 promoter stabilization and its transcription regulation. Gene Reports, 23, 101155. https://doi.org/10.1016/j.genrep.2021.101155

58. Majee, P., Jain, N., & Kumar, A.* (2021). Designing of a multi-epitope vaccine candidate against Nipah virus by in silico approach: A putative prophylactic solution for the deadly virus. Journal of Biomolecular Structure and Dynamics, 39(4), 1461–1480. https://doi.org/10.1080/07391102.2020.1734088

57. Dubey, A. R., Prasad, A., Poluri, K. M., Kumar, A., Kumar, A., & Mishra, A. (2021). Proteome Linked Biochemical Targets: Can Repair Defective Cellular Physiological Mechanisms? Cellular Physiology and Biochemistry, 55(S2), 49–70. https://doi.org/10.33594/000000350

56. Majee, P., Pattnaik, A., Sahoo, B. R., Shankar, U., Pattnaik, A. K., Kumar, A., & Nayak, D. (2021). Inhibition of Zika virus replication by G-quadruplex-binding ligands. Molecular Therapy – Nucleic Acids, 23, 691–701. https://doi.org/10.1016/j.omtn.2020.12.030

55. Pandya, N., Khan, E., Jain, N., Satham, L., Singh, R., Makde, R. D., Mishra, A., & Kumar, A*. (2021). Curcumin analogs exhibit anti-cancer activity by selectively targeting G-quadruplex forming c-myc promoter sequence. Biochimie, 180, 205–221. https://doi.org/10.1016/j.biochi.2020.11.006

54. Jain, N., Shankar, U., Majee, P., & Kumar, A.* (2021). Scrutinizing the SARS-CoV-2 protein information for designing an effective vaccine encompassing both the T-cell and B-cell epitopes. Infection, Genetics and Evolution, 87, 104648. https://doi.org/10.1016/j.meegid.2020.104648

53. Chatterjee, B., Kalyani, N., Anand, A., Khan, E., Das, S., Bansal, V., Kumar, A., & Sharma, T. K. (2020). GOLD SELEX: A novel SELEX approach for the development of high-affinity aptamers against small molecules without residual activity. Microchimica Acta, 187(11), 618. https://doi.org/10.1007/s00604-020-04577-0

52. Jain, N., Mishra, S. K., Shankar, U., Jaiswal, A., Sharma, T. K., Kodgire, P., & Kumar, A*. (2020). G-quadruplex stabilization in the ions and maltose transporters gene inhibit Salmonella enterica growth and virulence. Genomics, 112(6), 4863–4874. https://doi.org/10.1016/j.ygeno.2020.09.010

51. Taneja, V., Goel, M., Shankar, U., Kumar, A., Khilnani, G. C., Prasad, H. K., Prasad, G. B. K. S., Gupta, U. D., & Sharma, T. K. (2020). An Aptamer Linked Immobilized Sorbent Assay (ALISA) to Detect Circulatory IFN-α, an Inflammatory Protein among Tuberculosis Patients. ACS Combinatorial Science, 22(11), 656–666. https://doi.org/10.1021/acscombsci.0c00108

50. Shankar, U., Jain, N., Majee, P., Kodgire, P., Sharma, T. K., & Kumar, A.* (2020). Exploring Computational and Biophysical Tools to Study the Presence of G-Quadruplex Structures: A Promising Therapeutic Solution for Drug-Resistant Vibrio cholerae. Frontiers in Genetics, 11, 935. https://doi.org/10.3389/fgene.2020.00935

49. Majee, P., Shankar, U., Pasadi, S., Muniyappa, K., Nayak, D., & Kumar, A.* (2020). Genome-wide analysis reveals a regulatory role for G-quadruplexes during Adenovirus multiplication. Virus Research, 283, 197960. https://doi.org/10.1016/j.virusres.2020.197960

48. Shankar, U., Jain, N., Mishra, S. K., Sharma, T. K., & Kumar, A.* (2020). Conserved G-Quadruplex Motifs in Gene Promoter Region Reveals a Novel Therapeutic Approach to Target Multi-Drug Resistance Klebsiella pneumoniae. Frontiers in Microbiology, 11, 1269. https://doi.org/10.3389/fmicb.2020.01269

47. Kumar, S., Sharma, P. P., Shankar, U., Kumar, D., Joshi, S. K., Pena, L., Durvasula, R., Kumar, A., Kempaiah, P., Poonam, & Rathi, B. (2020). Discovery of New Hydroxyethylamine Analogs against 3CLpro Protein Target of SARS-CoV-2: Molecular Docking, Molecular Dynamics Simulation, and Structure–Activity Relationship Studies. Journal of Chemical Information and Modeling, 60(12), 5754–5770. https://doi.org/10.1021/acs.jcim.0c00326

46. Joshi, B., Kaur, J., Khan, E., Kumar, A., & Joshi, A. (2020). Ultrasonic atomizer driven development of doxorubicin-chitosan nanoparticles as anticancer therapeutics: Evaluation of anionic cross-linkers. Journal of Drug Delivery Science and Technology, 57, 101618. https://doi.org/10.1016/j.jddst.2020.101618
45. Shankar, U., Jain, N., Majee, P., Mishra, S. K., Rathi, B., & Kumar, A. (2020). Potential Drugs Targeting Nsp16 Protein May Corroborates a Promising Approach to Combat SARSCoV-2 Virus. ChemRxiv. https://doi.org/10.26434/chemrxiv.12279671.v1

44. Verma, A. K., Khan, E., Mishra, S. K., Mishra, A., Charlet-Berguerand, N., & Kumar, A.* (2020). Curcumin Regulates the r(CGG)exp RNA Hairpin Structure and Ameliorate Defects in Fragile X-Associated Tremor Ataxia Syndrome. Frontiers in Neuroscience, 14, 295. https://doi.org/10.3389/fnins.2020.00295

43. Agrawal, R., Goyal, V. D., Singh, R., Kumar, A., Jamdar, S. N., Kumar, A., & Makde, R. D. (2020). Structural basis for the unusual substrate specificity of unique two-domain M1 metallopeptidase. International Journal of Biological Macromolecules, 147, 304–313. https://doi.org/10.1016/j.ijbiomac.2019.12.239

42. Bhagwat, S. R., Hajela, K., Bhutada, S., Choudhary, K., Saxena, M., Sharma, S., & Kumar, A.* (2020). Identification of unexplored substrates of the serine protease, thrombin, using N-terminomics strategy. International Journal of Biological Macromolecules, 144, 449–459. https://doi.org/10.1016/j.ijbiomac.2019.12.137

41. Majee, P., Kumar Mishra, S., Pandya, N., Shankar, U., Pasadi, S., Muniyappa, K., Nayak, D., & Kumar, A.* (2020). Identification and characterization of two conserved G-quadruplex forming motifs in the Nipah virus genome and their interaction with G-quadruplex specific ligands. Scientific Reports, 10(1), 1477. https://doi.org/10.1038/s41598-020-58406-8

40. Verma, A. K., Khan, E., Bhagwat, S. R., & Kumar, A.* (2020). Exploring the Potential of Small Molecule-Based Therapeutic Approaches for Targeting Trinucleotide Repeat Disorders. Molecular Neurobiology, 57(1), 566–584. https://doi.org/10.1007/s12035-019-01724-4

39. Dhiman, A., Kumar, C., Mishra, S. K., Sikri, K., Datta, I., Sharma, P., Singh, T. P., Haldar, S., Sharma, N., Bansal, A., Ahmad, Y., Kumar, A., Sharma, T. K., & Tyagi, J. S. (2019). Theranostic Application of a Novel G-Quadruplex-Forming DNA Aptamer Targeting Malate Synthase of Mycobacterium tuberculosis. Molecular Therapy – Nucleic Acids, 18, 661–672. https://doi.org/10.1016/j.omtn.2019.09.026

38. Sharma, P., Kumar, A., & Singh, D. (2019). Dietary Flavonoids Interaction with CREB-BDNF Pathway: An Unconventional Approach for Comprehensive Management of Epilepsy. Current Neuropharmacology, 17(12), 1158–1175. https://doi.org/10.2174/1570159X17666190809165549

37. Khan, E., Mishra, S. K., Mishra, R., Mishra, A., & Kumar, A.* (2019). Discovery of a potent small molecule inhibiting Huntington’s disease (HD) pathogenesis via targeting CAG repeats RNA and Poly Q protein. Scientific Reports, 9(1), 16872. https://doi.org/10.1038/s41598-019-53410-z

36. Agrawal, R., Goyal, V. D., Kumar, A., Gaur, N. K., Jamdar, S. N., Kumar, A., & Makde, R. D. (2019). Two-domain aminopeptidase of M1 family: Structural features for substrate binding and gating in absence of C-terminal domain. Journal of Structural Biology, 208(1), 51–60. https://doi.org/10.1016/j.jsb.2019.07.010

35. Verma, A. K., Khan, E., Mishra, S. K., Jain, N., & Kumar, A.* (2019). Piperine Modulates Protein Mediated Toxicity in Fragile X-Associated Tremor/Ataxia Syndrome through Interacting Expanded CGG Repeat (r(CGG)exp ) RNA. ACS Chemical Neuroscience, 10(8), 3778–3788. https://doi.org/10.1021/acschemneuro.9b00282

34. Khan, E., Biswas, S., Mishra, S. K., Mishra, R., Samanta, S., Mishra, A., Tawani, A., & Kumar, A*. (2019). Rationally designed small molecules targeting toxic CAG repeat RNA that causes Huntington’s disease (HD) and spinocerebellar ataxia (SCAs). Biochimie, 163, 21–32. https://doi.org/10.1016/j.biochi.2019.05.001

33. Mishra, S. K., Shankar, U., Jain, N., Sikri, K., Tyagi, J. S., Sharma, T. K., Mergny, J.-L., & Kumar, A.* (2019). Characterization of G-Quadruplex Motifs in espB, espK, and cyp51 Genes of Mycobacterium tuberculosis as Potential Drug Targets. Molecular Therapy – Nucleic Acids, 16, 698–706. https://doi.org/10.1016/j.omtn.2019.04.022

32. Agrawal, R., Singh, R., Kumar, A., Kumar, A., & Makde, R. D. (2019). Crystal structures of pyrrolidone-carboxylate peptidase I from Deinococcus radiodurans reveal the mechanism of L -pyroglutamate recognition. Acta Crystallographica Section D Structural Biology, 75(3), 308–316. https://doi.org/10.1107/S2059798319000676

31. Ghosh, A., Ekka, M. K., Tawani, A., Kumar, A., Chakraborty, D., & Maiti, S. (2019). Restoration of miRNA-149 Expression by TmPyP4 Induced Unfolding of Quadruplex within Its Precursor. Biochemistry, 58(6), 514–525. https://doi.org/10.1021/acs.biochem.8b00880

30. Mishra, S. K., Jain, N., Shankar, U., Tawani, A., Sharma, T. K., & Kumar, A.* (2019). Characterization of highly conserved G-quadruplex motifs as potential drug targets in Streptococcus pneumoniae. Scientific Reports, 9(1), 1791. https://doi.org/10.1038/s41598-018-38400-x

29. Joshi, V., Mishra, R., Upadhyay, A., Amanullah, A., Poluri, K. M., Singh, S., Kumar, A., & Mishra, A. (2019). Polyphenolic flavonoid (Myricetin) upregulated proteasomal degradation mechanisms: Eliminates neurodegenerative proteins aggregation. Journal of Cellular Physiology, 234(11), 20900–20914. https://doi.org/10.1002/jcp.28695

28. Kaur, H., Bhagwat, S. R., Sharma, T. K., & Kumar, A.* (2019). Analytical Techniques for Characterization of Biological Molecules – Proteins and Aptamers/Oligonucleotides. Bioanalysis, 11(2), 103–117. https://doi.org/10.4155/bio-2018-0225

27. Das, R., Dhiman, A., Mishra, S. K., Haldar, S., Sharma, N., Bansal, A., Ahmad, Y., Kumar, A., Tyagi, J. S., & Sharma, T. K. (2019). Structural switching electrochemical DNA aptasensor for the rapid diagnosis of tuberculous meningitis. International Journal of Nanomedicine, Volume 14, 2103–2113. https://doi.org/10.2147/IJN.S189127

26. Dhiman, A., Anand, A., Malhotra, A., Khan, E., Santra, V., Kumar, A., & Sharma, T. K. (2018). Rational truncation of aptamer for cross-species application to detect krait envenomation. Scientific Reports, 8(1), 17795. https://doi.org/10.1038/s41598-018-35985-1

25. Kalra, P., Mishra, S. K., Kaur, S., Kumar, A., Prasad, H. K., Sharma, T. K., & Tyagi, J. S. (2018). G-Quadruplex-Forming DNA Aptamers Inhibit the DNA-Binding Function of HupB and Mycobacterium tuberculosis Entry into Host Cells. Molecular Therapy – Nucleic Acids, 13, 99–109. https://doi.org/10.1016/j.omtn.2018.08.011

24. Dhiman, A., Haldar, S., Mishra, S. K., Sharma, N., Bansal, A., Ahmad, Y., Kumar, A., Sharma, T. K., & Tyagi, J. S. (2018). Generation and application of DNA aptamers against HspX for accurate diagnosis of tuberculous meningitis. Tuberculosis, 112, 27–36. https://doi.org/10.1016/j.tube.2018.07.004

22. Bhagwat, S. R., Hajela, K., & Kumar, A.* (2018). Proteolysis to Identify Protease Substrates: Cleave to Decipher. PROTEOMICS, 18(13), 1800011. https://doi.org/10.1002/pmic.201800011

21. Kaur, H., Bruno, J. G., Kumar, A., & Sharma, T. K. (2018). Aptamers in the Therapeutics and Diagnostics Pipelines. Theranostics, 8(15), 4016–4032. https://doi.org/10.7150/thno.25958

20. Thakur, N., Sharma, B., Bishnoi, S., Mishra, S. K., Nayak, D., Kumar, A., & Sarma, T. K. (2018). Multifunctional Inosine Monophosphate Coordinated Metal–Organic Hydrogel: Multistimuli Responsiveness, Self-Healing Properties, and Separation of Water from Organic Solvents. ACS Sustainable Chemistry & Engineering, 6(7), 8659–8671. https://doi.org/10.1021/acssuschemeng.8b00963

19. Upadhyay, A., Amanullah, A., Mishra, R., Kumar, A., & Mishra, A. (2018). Lanosterol Suppresses the Aggregation and Cytotoxicity of Misfolded Proteins Linked with Neurodegenerative Diseases. Molecular Neurobiology, 55(2), 1169–1182. https://doi.org/10.1007/s12035-016-0377-2

18. Khan, E., Tawani, A., Mishra, S. K., Verma, A. K., Upadhyay, A., Kumar, M., Sandhir, R., Mishra, A., & Kumar, A.* (2018). Myricetin Reduces Toxic Level of CAG Repeats RNA in Huntington’s Disease (HD) and Spino Cerebellar Ataxia (SCAs). ACS Chemical Biology, 13(1), 180–188. https://doi.org/10.1021/acschembio.7b00699

16. Mishra, S. K., Jain, N., Shankar, U., Tawani, A., Mishra, A., & Kumar, A. (2018). SMMDB: A web-accessible database for small molecule modulators and their targets involved in neurological diseases. Database, 2018. https://doi.org/10.1093/database/bay082

15. Tawani, A., Mishra, S. K., & Kumar, A.* (2017). Structural insight for the recognition of G-quadruplex structure at human c-myc promoter sequence by flavonoid Quercetin. Scientific Reports, 7(1), 3600. https://doi.org/10.1038/s41598-017-03906-3

14. Kumar, A., Mishra, S., & Khan, E. (2017). Emerging Methods for Structural Analysis of Protein Aggregation. Protein & Peptide Letters, 24(4), 331–339. https://doi.org/10.2174/0929866524666170206123150

13. Joshi, V., Upadhyay, A., Kumar, A., & Mishra, A. (2017). Gp78 E3 Ubiquitin Ligase: Essential Functions and Contributions in Proteostasis. Frontiers in Cellular Neuroscience, 11, 259. https://doi.org/10.3389/fncel.2017.00259

12. Tawani, A., Amanullah, A., Mishra, A., & Kumar, A.* (2016). Evidences for Piperine inhibiting cancer by targeting human G-quadruplex DNA sequences. Scientific Reports, 6(1), 39239. https://doi.org/10.1038/srep39239

11. Mishra, S. K., Tawani, A., Mishra, A., & Kumar, A.* (2016). G4IPDB: A database for G-quadruplex structure forming nucleic acid interacting proteins. Scientific Reports, 6(1), 38144. https://doi.org/10.1038/srep38144

10. Joshi, V., Amanullah, A., Upadhyay, A., Mishra, R., Kumar, A., & Mishra, A. (2016). A Decade of Boon or Burden: What Has the CHIP Ever Done for Cellular Protein Quality Control Mechanism Implicated in Neurodegeneration and Aging? Frontiers in Molecular Neuroscience, 9. https://doi.org/10.3389/fnmol.2016.00093

9. Kumar Mishra, S., & Kumar, A.* (2016). NALDB: Nucleic acid ligand database for small molecules targeting nucleic acid. Database, 2016, baw002. https://doi.org/10.1093/database/baw002

8. Tawani, A., & Kumar, A.* (2015). Structural Insight into the interaction of Flavonoids with Human Telomeric Sequence. Scientific Reports, 5(1), 17574. https://doi.org/10.1038/srep17574

7. Tawani, A., & Kumar, A.* (2015). Structural Insights Reveal the Dynamics of the Repeating r(CAG) Transcript Found in Huntington’s Disease (HD) and Spinocerebellar Ataxias (SCAs). PLOS ONE, 10(7), e0131788. https://doi.org/10.1371/journal.pone.0131788

6. Hoskins, J. W., Ofori, L. O., Chen, C. Z., Kumar, A., Sobczak, K., Nakamori, M., Southall, N., Patnaik, S., Marugan, J. J., Zheng, W., Austin, C. P., Disney, M. D., Miller, B. L., & Thornton, C. A. (2014). Lomofungin and dilomofungin: Inhibitors of MBNL1-CUG RNA binding with distinct cellular effects. Nucleic Acids Research, 42(10), 6591–6602. https://doi.org/10.1093/nar/gku275

4. Kumar, A., Parkesh, R., Sznajder, L. J., Childs-Disney, J. L., Sobczak, K., & Disney, M. D. (2012). Chemical Correction of Pre-mRNA Splicing Defects Associated with Sequestration of Muscleblind-like 1 Protein by Expanded r(CAG)-Containing Transcripts. ACS Chemical Biology, 7(3), 496–505. https://doi.org/10.1021/cb200413a

3. Parkesh, R., Childs-Disney, J. L., Nakamori, M., Kumar, A., Wang, E., Wang, T., Hoskins, J., Tran, T., Housman, D., Thornton, C. A., & Disney, M. D. (2012). Design of a Bioactive Small Molecule That Targets the Myotonic Dystrophy Type 1 RNA via an RNA Motif–Ligand Database and Chemical Similarity Searching. Journal of the American Chemical Society, 134(10), 4731–4742. https://doi.org/10.1021/ja210088v

2. Kumar, A., Park, H., Fang, P., Parkesh, R., Guo, M., Nettles, K. W., & Disney, M. D. (2011). Myotonic Dystrophy Type 1 RNA Crystal Structures Reveal Heterogeneous 1 × 1 Nucleotide UU Internal Loop Conformations. Biochemistry, 50(45), 9928–9935. https://doi.org/10.1021/bi2013068

1. Kumar, A., Fang, P., Park, H., Guo, M., Nettles, K. W., & Disney, M. D. (2011). A Crystal Structure of a Model of the Repeating r(CGG) Transcript Found in Fragile X Syndrome. ChemBioChem, 12(14), 2140–2142. https://doi.org/10.1002/cbic.201100337

